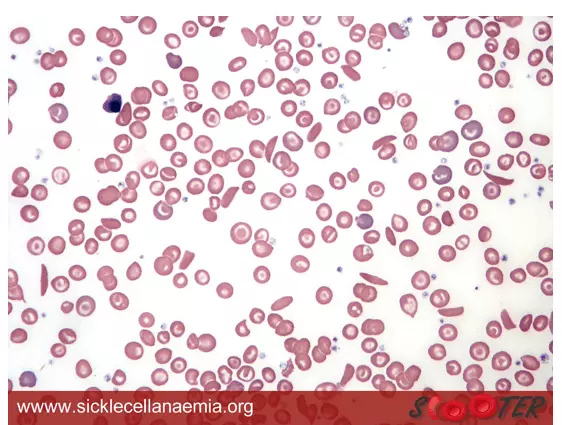
Sickle Cell Anaemia Blood Smear SimpleMed Sickle Cell Anaemia Blood Smear SimpleMed

Next Lesson - Enzymes and Regulation of Protein Function
Abstract
- Myoglobin is a globular protein formed of one polypeptide chain. It is important in acting as an intracellular storage of oxygen in muscle tissue.
- Haemoglobin is a tetrameric haem protein found within red blood cells. It transports oxygen from the lungs to tissues whilst returning carbon dioxide to the lungs from tissues.
- Haemoglobin has a lower affinity for oxygen compared to myoglobin, therefore myoglobin only unloads its oxygen molecule when oxygen levels within the muscle tissue are very low.
- Haemoglobin's affinity for oxygen can be decreased by 2,3-BPG, carbon dioxide and decreased pH, leading to increased oxygen offload.
- Carbon monoxide acts as a poison and binds at the same sites as oxygen on the haemoglobin structure. A patient suffering from carbon monoxide poisoning suffers from tiredness and dizziness.
- Haemoglobin present in the fetus has a different structure to that of adults. This difference results in fetal haemoglobin having a higher affinity for oxygen compared to the maternal adult haemoglobin which allows fetal haemoglobin to bind with oxygen from the maternal oxygenated haemoglobin in the placenta.
- Genetic mutations in the genes that produce globin chains can result in diseases such as sickle cell anaemia and thalassaemia.
- Red blood cells in sickle cell anaemia become sticky and polymerise at low partial pressures of oxygen. These cells are also more likely to lyse and have reduced flexibility compared to normal, healthy haemoglobin, so can block small blood vessels.
- Thalassaemia is split into two types: alpha thalassaemia and beta thalassaemia. The severity of the patient’s condition depends on how many of the four alpha or the two beta genes are missing.
Core
In this article, we are going to discuss the function of two important proteins that exist within the human body: haemoglobin and myoglobin.
Haemoglobin is the well-known haem protein that is found in red blood cells (RBCs) and carries oxygen from the lungs to the tissues whilst returning carbon dioxide back to the lungs from the tissues. Myoglobin is only found in muscle tissue and serves as an intracellular storage site of oxygen.
Myoglobin is a haem protein and is a monomeric protein (single polypeptide chain). The protein molecule has a globular structure and it is comprised of eight separate right-handed alpha helices that are connected by short non-helices regions.
Each myoglobin molecule contains a haem group with an iron ion (Fe2+) in it that binds with an oxygen molecule. When a myoglobin molecule is saturated with an oxygen molecule, it can be called oxymyoglobin and when it is unsaturated, it can be called deoxymyoglobin.

Image - The structure of myoglobin with the haem group surrounded by the rest of the protein
Public Domain source by AzaToth
Myoglobin is only found in muscle tissues and acts as a storage molecule for oxygen. Due to its very high affinity for oxygen, it will readily load oxygen in normal conditions which is only released in times of oxygen deprivation. In these anaerobic situations, the oxygen released from myoglobin can allow the muscle cells to carry on generating energy to contract.
Myoglobin binds firmly and tightly to oxygen molecules, and because of this it produces a hyperbolic curve on a graph.

Diagram - Graph of the hyperbolic curve when plotting the saturation of myoglobin against increasing partial pressures of oxygen. The myoglobin has a high affinity for oxygen due to the low partial pressure of oxygen required to give 50% saturation (P50)
SimpleMed original by Dr. Peter Parkinson
Haemoglobin is a tetrameric haem protein (four polypeptide chains) found in red blood cells (RBCs) and carries oxygen from the lungs to the tissues, whilst returning carbon dioxide from the tissues to the lungs to be expired out of the body.
Haemoglobin has a globular structure, with adult haemoglobin (HbA) being composed of two alpha polypeptide chains and two beta polypeptide chains forming a four subunit molecule.

Image - The structure of haemoglobin
Creative commons source by Zephyris [CC BY-SA 4.0 (https://creativecommons.org/licenses/by-sa/4.0)]
Within each subunit there is a prosthetic haem group containing an Fe2+, which binds the oxygen molecules. This means that each haemoglobin molecule can bind with a maximum of four oxygen molecules.

Diagram - The different chains that make up haemoglobin along with the haem groups
Creative commons source by OpenStax College, edited by Dr. Peter Parkinson [CC BY-SA 4.0 (https://creativecommons.org/licenses/by-sa/4.0)]
When haemoglobin is bound to oxygen it is called oxyhaemoglobin, and when it is not bound to oxygen it is called deoxyhaemoglobin. Deoxyhaemoglobin can exist in two states: low affinity T state or high affinity R state. When Fe2+ binds with an oxygen molecule, this promotes the stabilisation of the R state therefore leading to a change in the conformation of haemoglobin.
The oxygen dissociation curve for haemoglobin has a sigmoidal shape due to the cooperative binding of oxygen. At low partial pressures of oxygen, it is difficult for the first oxygen molecule to bind with haemoglobin as the protein molecule has low affinity (the protein is in the T state). After the first molecule of oxygen binds, there is a conformation change in the shape of haemoglobin making it easier for subsequent oxygen molecules to bind.

Diagram - Graph showing the oxygen disassociation curves for haemoglobin and myoglobin
SimpleMed original by Dr. Peter Parkinson
The sigmoidal shape of the oxygen disassociation curve of haemoglobin shows that oxygen can be transported around the body efficiently from the lungs to the tissues. When in the lungs, where the partial pressure of oxygen is high, haemoglobin molecules will be near 100% saturated due to the high affinity for oxygen at this partial pressure. As the partial pressure of oxygen decreases, the oxygen molecules are unloaded as haemoglobin’s affinity for oxygen decreases. This process occurs at peripheral tissues and allows for the oxygen to be offloaded to the tissues that have the highest requirement.
The P50 (partial pressure of oxygen to give 50% saturation) of haemoglobin is lower than that of myoglobin, therefore haemoglobin has a lower affinity for oxygen compared to myoglobin. This is important as myoglobin will continue to hold onto its oxygen molecule until the oxygen levels within muscles are very low whereas haemoglobin unloads its oxygen at higher partial pressure compared to myoglobin allowing tissues to continue to respire. This also means that haemoglobin will give up oxygen to myoglobin.

Diagram - Graph of the partial pressure of oxygen required for 50% saturation differs between myoglobin and haemoglobin
SimpleMed original by Dr. Peter Parkinson
There are a few factors that affect haemoglobin binding to oxygen and they can affect haemoglobin’s affinity of oxygen and shift the position of the oxygen dissociation curve.
2,3-Bisphosphoglycerate (2,3-BPG)
2,3-BPG is formed as an intermediate product of glycolysis, 1,3-BPG. This reaction to form 2,3-BPG from 1,3-BPG is catalysed by the enzyme BPG mutase.
2,3-BPG acts as an allosteric effector to haemoglobin and the molecule binds to the positively charged amino acid residues in the centre of the haemoglobin structure. Put simply, the effect of this is that in the presence of 2,3-BPG, haemoglobin stays in the T state, and as a result 2,3-BPG lowers the affinity of haemoglobin for oxygen. The overall effect therefore is that 2,3 BPG shifts the oxygen dissociation curve to the right and thus increases percentage of oxygen molecules unloaded at peripheral tissues.

Diagram: Graph showing the effect of 2,3-BPG on the affinity of haemoglobin for oxygen. Compare the blue line (Hb without 2,3-BPG) to the pink line (Hb with 2,3-BPG). Note how the pink line is shifted to the right in comparison to the blue line due to the presence of BPG and that at the same partial pressure of 20 (at the peripheral tissues) that the pink curve has a much lower oxygen saturation as the oxygen has been given to the respiring tissues.
SimpleMed original by Dr. Peter Parkinson
There are situations where a person may have a higher than expected 2,3-BPG levels due to low tissues oxygen concentrations. These include if the person has acclimatised to living at higher altitudes or if a person is suffering from congestive heart failure (CHF). In CHF as the RBCs will be stimulated to generate more 2,3-BPG due to changes in the pH and oxygen levels, which affect the enzymes that produce and break down 2,3-BPG. At high altitudes there is less oxygen, so the increased level of 2,3-BPG means the RBCs can release more oxygen at lower partial pressures of oxygen.
Carbon Dioxide and Hydrogen Ions
Carbon dioxide and hydrogen ions can both bind to haemoglobin. By binding, they lower haemoglobin’s affinity for oxygen therefore increasing the unloading of oxygen molecules.
There is a relationship between the pH of the blood and the partial pressure of carbon dioxide, which is mediated by the enzyme carbonic anhydrase. This enzyme converts carbon dioxide to carbonic acid and releases a H+ ion in the process, which lowers the pH of the surrounding blood.
In actively respiring tissues, there is a large amount of carbon dioxide produced through increased metabolism. As a result of the action of carbonic anhydrase, this leads to a lowered pH of the local blood. This causes haemoglobin’s affinity for oxygen to decrease, hence a greater amount of oxygen will be provided to actively respiring tissues through increased unloading.
The overall physiological effect of decreasing pH and increased carbon dioxide concentration leading to decreased affinity of haemoglobin for oxygen, is called the Bohr effect. This effect enhances the unloading of oxygen in metabolically active tissues and ensures the delivery of oxygen meets the demands of the tissues.
The Bohr effect will shift the oxygen disassociation curve to the right hence increasing the P50 of haemoglobin therefore reducing the affinity of haemoglobin for oxygen. Other factors that shift the oxygen disassociation curve to the right are increased temperature (also seen when respiration is increased) and increased 2,3-BPG concentration. This can be remembered by saying that 'BohR is Right'.

Diagram - Shows the Bohr effect for haemoglobin with the green line indicating the change when the factors listed on the left of the curve are true, the red line indicating the same for factors listed on the right.
Creative commons source by Ratznium at English Wikipedia Later versions were uploaded by Aaronsharpe at en.wikipedia, edited by Dr. Peter Parkinson [CC BY-SA 4.0 (https://creativecommons.org/licenses/by-sa/4.0)]
Carbon monoxide acts as a poison as it combines with myoglobin and haemoglobin, blocking the transport of oxygen. Carbon monoxide binds at the same sites as oxygen does, but binds more tightly. Because of this, carbon monoxide cannot be easily released and as a result this subunit of haemoglobin can not transport oxygen. After carbon monoxide binds to a subunit of a haemoglobin molecule, the affinity of the unaffected subunits for oxygen increases and oxygen bound to these subunits is retained within the molecule.
As a result, an accumulation of carbon monoxide-bound haemoglobin molecules can occur which leads to fewer haemoglobin molecules being able to bind and deliver oxygen to tissues.
On the oxygen disassociation curve of haemoglobin, the curve will shift to the left when carbon monoxide is present and shows the increased affinity for oxygen haemoglobin has due to a reduced P50 value.
A patient suffering from carbon monoxide poisoning will experience symptoms such as dizziness, tiredness and unconsciousness due to oxygen deprivation. Carbon monoxide poisoning can be fatal when there are very high levels of carboxyhaemoglobin in the blood (often >50% COHb), due to severe oxygen deprivation.

Diagram - Graph showing the oxygen disassociation curve for haemoglobin when carbon monoxide is present
SimpleMed original by Dr. Peter Parkinson
During development, the haemoglobin present in a fetus (HbF) is different to that present in an adult, this is due to the regulation of genes that lead to production of the haemoglobin molecules. In a fetus, the haemoglobin molecule is made up of two alpha chains and two gamma chains, with the gene responsible for the production of the gamma chains being inactivated around six months postnatally. After the gene responsible for the gamma chains is inactivated, the gene that produces beta chains will begin to be transcribed. The gene responsible for production of alpha chains is transcribed from the beginning of development and is never replaced.
HbF has a greater affinity for oxygen compared to adult haemoglobin (HbA) which allows HbF to bind with oxygen from the maternal oxyhaemoglobin in the placenta. The increased affinity is due to the lack of interaction between fetal haemoglobin and 2,3-BPG; the gamma subunit present in HbF does not allow 2,3-BPG to bind as efficiently as it would with the subunits of HbA. This greater affinity for oxygen present within HbF allows the transfer of oxygen from the mother to the fetus, and also shifts the oxygen disassociation curve to the left.

Diagram - Graph showing the oxygen disassociation curve for fetal haemoglobin compared to adult haemoglobin
Creative commons source by OpenStax College [CC BY-SA 4.0 (https://creativecommons.org/licenses/by-sa/4.0)]
Sickle cell anaemia is the most common type of the sickle cell diseases and the condition has an autosomal recessive inheritance pattern. There is an estimated 15,000 people suffering from the condition in the UK at present. The disease is most commonly seen among those of Afro-Caribbean descent.
The genetic mutation leads to a single nucleotide mutation that results in the amino acid glutamate being replaced with valine in the beta globin chain of haemoglobin. The haemoglobin present in patients suffering from sickle cell anaemia is referred to as haemoglobin S (HbS) compared to HbA in a normal adult. Glutamate in HbA has hydrophilic properties whereas valine in HbS has hydrophobic properties.
At normal oxygen partial pressures, HbS has no change in the secondary, tertiary or quaternary structure of the molecule. However, at low oxygen partial pressures, the valine amino acid residues cause the haemoglobin molecules to become sticky before polymerising; the affected RBCs can form sickle or crescent shape.
Image - Blood smear of a patient with sickle cell anaemia. The sickle cells have a sickle or crescent shape
Creative commons source by scooterdmu [CC BY-SA 4.0 (https://creativecommons.org/licenses/by-sa/4.0)]
Red blood cells with HbS present are more prone to lyse, which can lead to the patient suffering from a haemolytic anaemia. The affected RBCs are also more rigid due to their reduced flexibility, meaning they can block small blood vessels, partly because of their shape. This leads to pain and organ damage due to reduced tissue perfusion.

Diagram - How sickle cells can block small blood vessels leading to organ damage
Creative commons source by Diana grib, edited by Dr. Peter Parkinson [CC BY-SA 4.0 (https://creativecommons.org/licenses/by-sa/4.0)]
At present, the only cure for sickle cell anaemia is a stem cell transplant. Without the cure, patients have to take various medications to reduce the symptoms of the disease. Patients must also have vaccinations to prevent becoming ill from diseases such as meningitis due to extensive damage suffered by the spleen leading to a damaged immune system (especially versus encapsulated bacteria including N. meningitidis).
Thalassaemias are a group of inherited blood disorders where there is an imbalance between the number of alpha and beta globin chains due to an abnormal production of the affected globin chain. There are two types of thalassaemia: alpha-thalassaemia and beta-thalassaemia.
The severity of the patient’s condition depends on how many of the four alpha genes or how many of the two beta genes are missing. To describe the severity of the patient’s conditions, words such as trait, minor, intermedia and major can be used; with trait describing a patient who has no symptoms at all or very mild anaemia and with major describing a patient who has severe symptoms and is dependent on blood transfusions as treatment.
Signs and symptoms of thalassaemia include weakness, fatigue, slow growth and pale/yellowish skin.
There is decreased or absent alpha-globin chain production. In alpha-thalassaemia, the beta globin chains can form stable tetramers with increased affinity for the oxygen molecules. This means it is harder to unload oxygen at peripheral tissues and the onset of the condition is before the birth of the patient.
There are several levels of severity because there are four genes that produce alpha chains with the severity of the symptoms depending on how many genes are missing. If one gene is missing then the patient may not have any symptoms or very mild symptoms, whereas if all four genes are missing, will cause hydrops fetalis and the fetus will not be compatible with life.
There is decreased or absent beta-globin chain production. With beta-thalassaemia, the alpha chains are unable to form stable tetramers in the haemoglobin molecule. Symptoms of the condition will present after birth and if one of the two genes is missing, the baby will have mild symptoms whereas if both genes are missing then the symptoms will be more severe.
Edited by: Dr. Ben Appleby
Reviewed by: Dr. Thomas Burnell
- 12730

